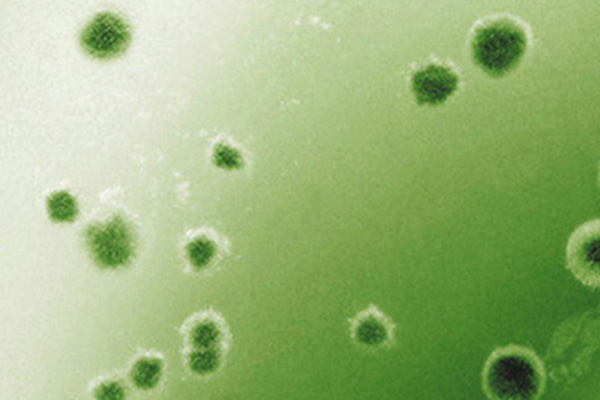
Schimmel in Innenräumen stoppen

- Unternehmen
- Leitthemen
- Gesundheit
Gesundheit
Für mehr Wohlbefinden und Wohngesundheit
Lebenslange Gesundheit ist eines der wichtigsten Bedürfnisse des Menschen. Innenräume spielen hierbei eine bedeutende Rolle - insbesondere vor dem Hintergrund, dass wir uns in ihnen die meiste Zeit unseres Lebens aufhalten. Doch es gibt verschiedene Faktoren, die das Wohlbefinden in den eigenen vier Wänden und letztlich unsere Gesundheit beeinflussen, darunter die Raumtemperatur, die Raumluft, die Luftfeuchtigkeit, die Raumakustik und der Tageslichteinfall. Zu einem gesunden Wohnkonzept zählt daher eine optimale Balance dieser sowie weiterer Faktoren.
Unsere fünf Säulen für mehr Wohngesundheit

Das bedeutet gute Raumluft für uns
Raumluft ist für unsere Gesundheit und unser Wohlbefinden essenziell, denn der Mensch atmet sie über 80% des Tages ein. Die Qualität der Raumluft hängt zu einem großen Teil davon ab, ob Oberflächen und Beschichtungen frei sind von Schadstoffen. Neben Lösemitteln rücken dabei auch zunehmend Konservierungsmittel in das Blickfeld. Allergiker geeignete, konservierungsmittel-, lösemittel- und weichmacherfreie Wandfarbe sorgt für ein Plus an Sicherheit und ein angenehmes Raumklima. Kinderzimmer, Wohnzimmer und Schlafzimmer verwandeln sich durch den Einsatz wohngesunder Innenraumfarben in schadstofffreie Wohlfühlorte.
Caparol hält ein Sortiment an leistungsstarken Innenfarben bereit, die zu einer guten Raumluft beitragen und so für ein Plus an Wohnqualität sorgen.
Unser Beitrag an einigen Beispielen und Referenzen

Das bedeutet ausgeglichene Raumfeuchtigkeit für uns
Die Luftfeuchtigkeit, auch Luftfeuchte genannt, gibt an, wie viel Wasserdampf in der Raumluft vorhanden ist. Es ist ein wichtiger Wert, denn eine zu niedrige oder zu hohe Luftfeuchte kann gesundheitliche Folgen nach sich ziehen, darunter Erkältungskrankheiten oder Atemwegsbeschwerden. Als ideale Luftfeuchtigkeit gilt, wenn bei einer Raumtemperatur von 20°C die Luftfeuchte zwischen 40 bis 60% beträgt.
Feuchtigkeitsregulierende Oberflächen, wie zum Beispiel mineralische Beschichtungen, sorgen für ein ausbalanciertes Raumklima und verringern so das Risiko von Kondenswasserbildung oder Lufttrockenheit und können so Schimmel vorbeugen oder stoppen.
Unser Beitrag an einigen Beispielen und Referenzen

Das bedeutet ausgeglichene Raumtemperatur für uns
Das eigene Zuhause soll ein Ort der Behaglichkeit und Gemütlichkeit sein – Zugluft möchte niemand haben. Bei diesem Thema steht die Wärmedämmung im Fokus: Eine korrekt ausgeführte Wärmedämmung erhöht die Temperatur der Innenwandflächen und beugt damit der Gefahr von thermischer Zugluft vor. Des Weiteren hilft sie dabei, die Energieeffizienz von Gebäuden zu erhöhen, Heizenergie zu sparen, klimaschädliche CO2-Emissionen zu reduzieren und über das gesamte Jahr hinweg eine ausgeglichene Raumtemperatur sicherzustellen.
Sie wurde entwickelt, um aus dem eigenen Zuhause den perfekten Wohlfühlort zu kreieren. Denn manchmal haben kaum sichtbare Produkte die größte Wirkung – mit dem Gefühl, die beste Entscheidung für die Zukunft zu treffen.
Unser Beitrag an einigen Beispielen und Referenzen

Das bedeutet ausreichend Tageslicht für uns
Wohngesundheit bedeutet auch, für ausreichend Licht in Lebensräumen Sorge zu tragen. Licht – allen voran Tageslicht – dient dabei nicht nur als Helligkeits-Lieferant, sondern hat auch großen Einfluss auf unsere Gesundheit und Stimmung. Denn die Sonnenstrahlen kurbeln die körpereigene Produktion des Glückshormons Serotonin an, das uns fit und leistungsfähig macht.
Caparol ist sich der Bedeutung von Licht bewusst und hat Farben und Wärmedämmungen entwickelt, die für mehr Licht im Raum verhelfen und somit zu einem Plus an Wohngesundheit und Wohlfühlatmosphäre beitragen.
Unser Beitrag an einigen Beispielen und Referenzen

Das bedeutet optimale Akustik für uns
Höhere Konzentration, bessere Sprachverständlichkeit, deutlich weniger Lärm: beim Thema Wohngesundheit kommt der Akustik eine wichtige Rolle zu. Sie hat das Ziel, harte Schallreflexionen zu vermeiden und den allgemeinen Lärmpegel zu senken – und somit Stress zu minimieren. Eine optimale Akustik steigert zudem das individuelle Wohlbefinden und den subjektiv empfundenen Wellness-Faktor eines Raumes.
Wir bieten ein fein aufeinander abgestimmtes Produktsortiment, das alle Anforderungen an eine optimale Raumakustik sicher abdeckt, an. Und das Beste: Auch in Sachen Optik gehen die Systemkomponenten keine Kompromisse ein.